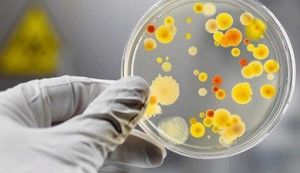

Цитомегаловірус (ЦМВ) відноситься до герпесвірусів сімейства Herpesviridae, був відкритий в кінці XIX століття. У той давній час хвороба, викликану цим вірусом, називали «поцелуйной» - передбачалося, що передача інфекції проходила при контакті зі слиною хворої людини, і лише в 1956 році був виявлений офіційний збудник хвороби - цитомегаловірус.
Це дуже поширене захворювання про існування і протягом, якого багато людей навіть і не підозрюють, так як при стабільно нормальному стані імунітету симптоми цитомегаловірусу ніяк про себе не заявляють. І лише при обстеженні на інші хвороби лабораторним методом з'ясовується його присутність в організмі.
За статистичними спостереженнями ця форма герпетичної інфекції постійно «проживає» у більше 70% населення земної кулі - один раз потрапивши в клітини організму, залишається там до кінця життя.
Клінічні прояви і симптоми цитомегаловірусу
Форми отримання вірусу
Медичні дослідження класифікували ознаки цитомегаловірусу на вроджену та набуту форму отримання вірусу:
- Вроджена форма ЦМВ Вроджена форма (гострий або хронічний процес) - від матері при внутрішньоутробному виношуванні, проході через родові шляхи. Якщо зараження відбувається в період перших трьох місяців вагітності, плід може загинути або отримати значні вади розвитку, такі як: вроджене каліцтво, недорозвиненість органів, водянка головного мозку, серцеві, печінкові патології, ДЦП, проблеми з психомоторикою і інші.
Ознаки цитомегаловірусу вродженого характеру: жовтяниця, збільшена печінка і селезінка, анемія, синюваті плями по тілу, неврологічні порушення, гідроцефалія головного мозку, уповільнене розумовий і фізичний розвиток, пошкодження судин головного мозку. Іноді симптоми проявляються не відразу, а до 3 місяців життя. Якщо ознаки цитомегаловірусу з'являються до 2-3 років, то крім патологій внутрішніх органів може бути розвиток проблем зі слухом, зором, затримки мовного і розумового розвитку.
Потрапивши в організм при народженні, цитомегаловірус викликає гострий перебіг інфекції або перетвориться відразу в латентну фазу, якщо імунітет порушується, відбувається активація вірусу з наступним хронічним перебігом.Симптоми цитомегаловірусу, при клінічній фазі перебігу хвороби складно діагностувати, так як в схожості ознак можна запідозрити інші захворювання, такі, як сифіліс, токсоплазмоз, лістеріоз, гемолітична хвороба та інші.
ЦМВ при слабкому стані імунітету

У людей, з пересадкою органів, вірус вражає донорські біологічні матеріали і органи. Наприклад, якщо пересадили печінку - виникає гепатит, при пересадки легенів - пневмонію, пересадці кісткового мозку - запалення легеневої тканини, з високою ймовірністю летального результату. Цитомегаловірус основний активатор опортуністичних ознак при СНІДі та ВІЛ-інфекції, викликає безліч нездужань, таких як запалення легенів, гепатит, енцефаліт, Рітіні, всілякі виразкові ураження шлунково-кишкової системи. Пошкодження багатьох систем організму цитомегаловірусом, на тлі імунодефіциту може привести до летального результату.
Цитомегаловірус у чоловіків
Цитомегаловірус у чоловіків - крім клінічних проявів симптомів ГРВІ вірус локалізується вогнищем запалення в сечостатевих органах, викликаючи неприємні хворобливі процеси в яєчках, сечівнику, простаті. Якщо цитомегаловірус у чоловіків протікає без виражених симптомів, то лікувати не потрібно і вся профілактика складається в організації здорового способу життя, зміцнення захисних сил, уникненні стресів, перевантаження ЦНС, щоб не викликати загострення.
Цитомегаловірус у жінки
Цитомегаловірус у жінки - представляє велику небезпеку, ніж цітамегаловірус у чоловіків. Пов'язано це з виношуванням плоду і дітонародженням. Якщо вірус викликав інфікування плода під час вагітності. то це можуть бути причиною виникнення патологій, зараження може призвести до загибелі дитини.
При годуванні малюка грудьми. інфікованої мамі потрібно проконсультуватися з лікарем, пройти лабораторне обстеження, щоб з'ясувати в якій стадії захворювання, так само перевірити дитини на наявність вірусу. Вагітним жінкам, у яких немає цього вірусу в організмі, потрібно бути обережними з потенційними джерелами зараження, не користуватися загальними побутовими засобами і посудом. Цитомегаловірус у жінки може викликати запальні процеси шийки і порожнини матки, яєчників, піхви. симптоми цитомегаловірусу
способи зараження

- Повітряно-краплинним шляхом.
- При сексуальних контактах.
- Через переливання крові і трансплантації органів.
- При проходженні через родові шляхи, під час народження.
- Від матері під час вагітності.
- Під час грудного вигодовування.
лікування цитомегаловірусу
В основному, після зараження вірусом організм адекватно переносить первинний запальний процес, виробляючи специфічні антитіла і лікувати його немає необхідності. Але сам вірус не зникає, зберігається довічно і при падінні імунітету може проявитися, з можливими ускладненнями. Лікувати цитомегаловірус варто тільки в тих ситуаціях, якщо є загроза життю. Визначити ступінь тяжкості захворювання і підібрати необхідну терапію може тільки лікар.
Необхідно лікування цитомегаловірусу, при наступних проявах
- Генералізована стадія з великим ураженням внутрішніх органів, на тлі присутності іншої вірусної інфекції, що ослаблює захисні функції організму.
- Загострення і ускладнення цитомегаловірусу при трансплантації органів, лікуванні онкологічних захворювань - в випадках застосування терапії придушення імунітету.
- Вроджені і набуті стану імунодефіциту.
- Первинний цитомегаловірус у жінки під час вагітності, особливо в першому триместрі.
Лікування цитомегаловірусу медикаментозними препаратами
- Лікування цитомегаловірусу противірусними засобами, що пригнічують активність інфекції, такими, як панавір, ганцикловір, цидофовир, фосканет (порошки, ін'єкції, гель для зовнішнього застосування).
- Для знищення вірусних частинок, підходять препарати групи імуноглобулінів: цитотект, неоцітотект, мегалотект (ін'єкції, розчини, краплі).
- Стимулюючі і зміцнюють імунну систему, імумономодуляторної препарати: Роферон А, Лейкинферон, Неовир, Генферон, Віферон (свічки, таблетки капсули).
- Спеціалізовані ліки для відновлення пошкоджених органів і тканин при ускладненнях, до них можна віднести лікування антибіотиками, що загоюють мазями, протизапальними засобами (таблетки, капсули, ін'єкції, свічки, мазі, гелі, краплі). Варто зауважити, що антибіотики призначаються не для лікування вірусу, а при додаткових захворюваннях, спровокованих інфекцією.
- Препарати, спрямовані на симптоматичне лікування знеболюючими, протизапальними засобами.
- Для підтримки захисних сил організму застосовують різні препарати вітамінно-мінеральних комплексів.
Цитомегаловірус у чоловіків, при необхідності терапії, зазвичай лікують, застосовуючи противірусні препарати: Фоскарнет, Віферон. Ганцикловір, а також іммуноглобуліновие препарати Цітотект, Мегалотект.
Цитомегаловірус у жінки - лікують, використовуючи противірусні засоби такі, як Ацикловір і всі його похідні, інтерферони - Віферон, Циклоферон, Генферон, використовують імуноглобуліни, що виробляють пасивну захист організму.
Лікування народними засобами
Лікування інфекції і ускладнень не повинно відбуватися самостійно, без нагляду лікаря.
Але використання паралельно з медикаментозними засобами і препаратами може бути ефективно, як профілактична і підтримуюча мера.
Для підняття імунітету народними засобами добре зарекомендували себе ехіноцея, лимонник, женьшень, левзея, різні трав'яні збори і відвари таких рослин, як деревій, богульник, нирки берези, череда, корінь солодки, шипшина, Шабельник і багато інших. Банальні цибулю і часник своїми фітонцидні властивості можуть захищати від вірусу і пригнічувати розвиток інфекції.
Мед і всі продукти бджільництва вважаються дуже ефективними народними засобами при ослабленому організмі.